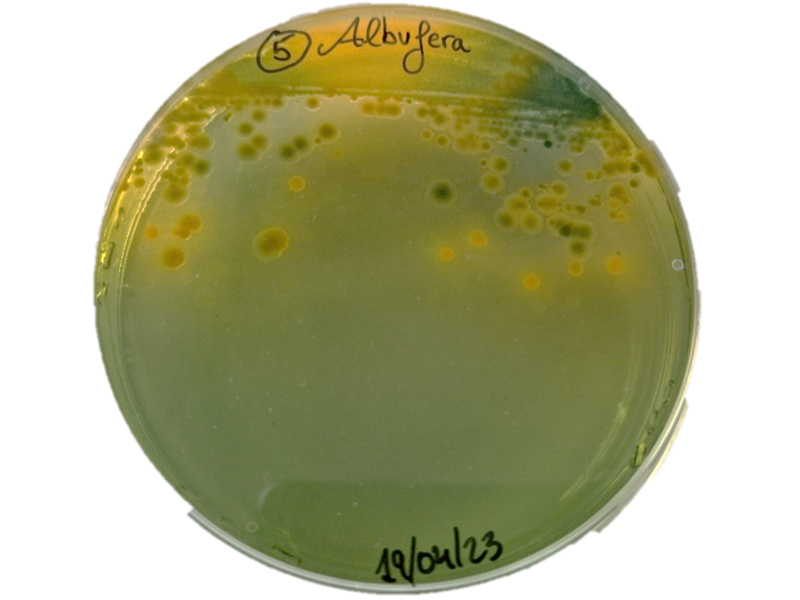

Some of our group staff have visited the Albufera de València site once again to collect water samples and try to detect and isolate different species of the genus Vibrio.
In an important scientific initiative, our group carried out an exhaustive water sampling in the Albufera of Valencia on 19 April 2023. The main objective of this research was to detect the presence of three bacteria of interest, Vibrio vulnificus (V. vulnificus), Vibrio harveyi (V. harveyi) and Vibrio metoecus (V. metoecus), in this aquatic ecosystem.
The Albufera of Valencia, considered one of the most important wetlands in Europe, is home to a great diversity of flora and fauna, being a favourable habitat for the development of various microorganisms. Among them, some species of the genus Vibrio, which are expanding due to climate change, have aroused the interest of scientists due to their potential impact on human health and aquaculture.
V. vulnificus is a fish pathogen and zoonotic (transmissible from animals to humans) bacterium that can cause severe infections in immunocompromised individuals, as well as less severe infections in healthy individuals who come into direct contact with contaminated water. On the other hand, V. harveyi is a marine pathogenic bacterium of invertebrates (shrimps, bivalves) and fish (sea bass, sea bream, sole...) that has been recognised as one of the major causes of vibriosis worldwide. Finally, V. metoecus is an opportunistic aquatic pathogen that usually coexists with Vibrio cholerae (V. cholerae) and has been recently discovered (year 2014), so much is still unknown about it.
Sampling was carried out by collecting water from different points of the Albufera (Albufera jetty, Gola de Pujol, Perellonet...). The temperature and salinity conditions of each point sampled were also recorded. Once in the laboratory, the samples underwent enrichment with Alkaline Peptone Water (APA) supplemented with 1.5% sodium chloride (NaCl) for the isolation of V. vulnificus and V. metoecus; and 3% NaCl for the isolation of V. harveyi, as it is a halophilic bacterium. After a 6-hour incubation period at 28°C, the enriched samples were plated on VVM (V. vulnificus selective medium), TCBS (selective and differential medium for different Vibrios, such as V. harveyi, V. choleare or Vibrio mimicus) and VMM (V. metoecus selective medium).
After 18-24 hours of incubation of the plates, the colonies grown on the different media were observed. V. vulnificus colonies appear green in TCBS medium and yellow in VVM medium (Figures 1 and 2), while both V. harveyi and V. cholerae colonies are yellow in TCBS medium (hence the increased salinity of the medium in an attempt to promote the growth of V. harveyi on V. cholerae).

The isolated colonies were verified by phenotypic (API 20E strip, Biomerieux, Figure 3) and genetic (PCR with specific oligonucleotides for the detection of different Vibrios species, Figure 4) methods to check their correct identification.


And what did we get out of this? Both V. vulnificus and V. mimicus were isolated and the presence of V. metoecus was detected by PCR, although the latter could not be isolated because it was in a viable but non-culturable (VBNC) state. The negative part? The salinity was so low (about 0.2 %) that V. harveyi could not be isolated or detected.
However, the fact that in a month like April V. vulnificus is detected in the Albufera de Valencia, a pathogen typical of warm climates, warns about the emergence of climate change. These pathogens have been underestimated for a very long time and the detriment of climatic conditions by human action will only aggravate this situation, endangering not only aquatic ecosystems and fish farms, but also our own health.